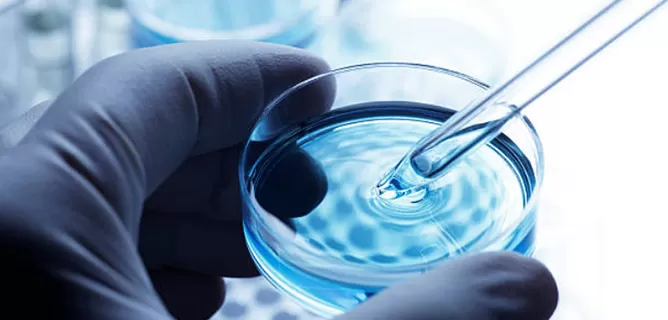
Cas9 Expression Plasmids

Custom plasmids with U6 or other promoters for gRNA transcription.
Vectors for constitutive or inducible Cas9 expression.

Plasmids designed to express multiple gRNAs from a single construct.

Vectors with fluorescent reporters or antibiotic resistance for enrichment.
Automated platforms for fast and accurate plasmid construction.
Full-length sequencing to guarantee plasmid integrity.
Wide range of standard and custom backbones available.
Assistance from design to delivery for your specific application.